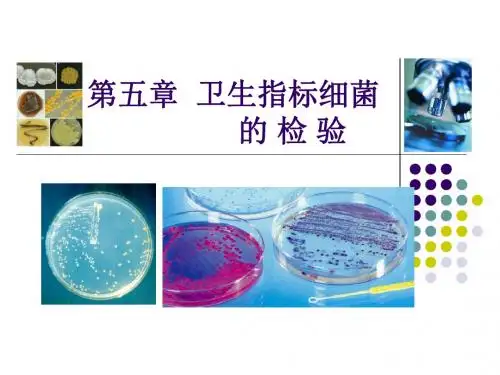

第五章卫生指标菌的检测OK
- 格式:ppt
- 大小:1.22 MB
- 文档页数:74



⼤肠杆菌不断随粪便排出体外,污染周围环境和⽔源、⾷品等。
取样检查时,样品中⼤肠杆菌越多,表⽰样品被粪便污染越严重,也表明样品中存在肠道致病菌的可能性越⼤。
故应对饮⽔、⾷品、饮料进⾏卫⽣细菌学检查。
1.细菌总数:检测每毫升或每克样品中所含细菌数,采⽤倾注培养计算。
我国规定的卫⽣标准是每毫升饮⽔中细菌总数不得超过100个。
2.⼤肠菌数指数:指每⽴升中⼤肠菌群数,采⽤乳糖发酵法检测。
我国的卫⽣标准是每1000ml饮⽔中不得超过3个⼤肠菌群;瓶装汽⽔、果汁等每100ml⼤肠菌群不得超过5个。

手卫生微生物学检测的标准
手卫生微生物学检测的标准主要包括细菌菌落总数的合格标准。
普通手卫生的细菌菌落数应≤10cfu/cm²,而外科手消毒的细菌菌落数应≤5cfu/cm²。
这意味着在手卫生消毒后,每平方厘米的手部皮肤上,细菌的数量不应超过这些标准。
此外,手卫生消毒效果的监测还应考虑不同环境下的手合格标准。
例如,在Ⅰ类和Ⅱ类区域,细菌菌落总数应≤5cfu/cm²;在Ⅲ类区域,细菌菌落总数应≤10cfu/cm²;在Ⅳ类区域,细菌菌落总数应≤15cfu/cm²。
这些标准旨在确保手部卫生在不同环境下都能达到一定的卫生标准,从而减少细菌感染的风险。
总的来说,手卫生微生物学检测的标准是确保手部清洁和卫生,减少细菌数量,以降低感染的风险。
医务人员和公众都应遵循这些标准,并定期进行手部卫生检测,以确保手部的卫生状况符合要求。

细菌的一般检验方法细菌的检验是微生物学中非常重要的一环,它可以帮助我们了解细菌的种类、数量和特性,为疾病的预防和治疗提供重要依据。
而细菌的一般检验方法则是我们进行细菌检验的基础,下面将为大家介绍几种常用的细菌检验方法。
首先,我们来介绍细菌培养法。
这是一种最常见的检验方法,通过在适当的培养基上培养细菌,观察其形态、生长速度、产生的色素等特征来进行鉴定。
细菌培养需要严格控制培养条件,包括温度、湿度、氧气浓度等,以保证细菌能够正常生长。
在培养基上形成的细菌菌落可以通过形态学和生理生化试验来进一步鉴定。
其次,酶标记法也是一种常用的细菌检验方法。
这种方法利用细菌产生的特定酶来进行检测,常见的有氧化酶、还原酶、水解酶等。
通过对细菌培养基添加特定底物,观察产生的色素变化或气体释放等现象,可以判断细菌的种类和数量。
另外,PCR法也是一种快速而准确的细菌检验方法。
PCR法是一种利用DNA聚合酶链式反应来扩增细菌DNA的技术,通过特定引物引导下,可以在短时间内扩增出目标细菌的DNA片段,再通过电泳或其他方法进行鉴定。
除了上述方法,还有一些免疫学方法也常用于细菌的检验,比如ELISA法和免疫胶体金法。
这些方法利用细菌与抗体的特异性结合来进行检测,具有高灵敏度和高特异性。
细菌的一般检验方法虽然多种多样,但每种方法都有其适用的范围和局限性。
在进行细菌检验时,我们需要根据具体的情况选择合适的方法,并结合多种方法进行综合分析,以确保检验结果的准确性和可靠性。
总的来说,细菌的一般检验方法是微生物学研究的基础,它为我们提供了解细菌特性和行为的重要手段。
通过不断的研究和实践,我们可以不断完善和发展细菌检验方法,为保障公共卫生安全和疾病防治提供更可靠的技术支持。
希望本文所介绍的内容能够对您有所帮助,谢谢阅读!。


菌落总数的检测方法一、菌落总数介绍:菌落是指细菌在固体培养基上生长繁殖而形成的能被肉眼识别的生长物,它是由数以万计相同的细菌集合而成。
当样品被稀释到一定程度,与培养基混合,在一定培养条件下,每个能够生长繁殖的细菌细胞都可以在平板上形成一个可见的菌落。
菌落总数就是指在一定条件下(如需氧情况、营养条件、pH、培养温度和时间等)每克(每毫升)检样所生长出来的细菌菌落总数。
按国家标准方法规定,即在需氧情况下,37℃培养48h,能在普通营养琼脂平板上生长的细菌菌落总数,所以厌氧或微需氧菌、有特殊营养要求的以及非嗜中温的细菌,由于现有条件不能满足其生理需求,故难以繁殖生长。
因此菌落总数并不表示实际中的所有细菌总数,菌落总数并不能区分其中细菌的种类,所以有时被称为杂菌数,需氧菌数等。
菌落总数测定是用来判定食品被细菌污染的程度及卫生质量,它反映食品在生产过程中是否符合卫生要求,以便对被检样品做出适当的卫生学评价。
菌落总数的多少在一定程度上标志着食品卫生质量的优劣。
二、检验方法菌落总数的测定,一般将被检样品制成几个不同的10倍递增稀释液,然后从每个稀释液中分别取出1mL置于灭菌平皿中与营养琼脂培养基混合,在一定温度下,培养一定时间后(一般为48小时),记录每个平皿中形成的菌落数量,依据稀释倍数,计算出每克(或每ml)原始样品中所含细菌菌落总数。
基本操作一般包括:样品的稀释--倾注平皿--培养48小时--计数报告。
国内外菌落总数测定方法基本一致,从检样处理、稀释、倾注平皿到计数报告无何明显不同,只是在某些具体要求方面稍有差别,如有的国家在样品稀释和倾注培养进,对吸管内液体的流速,稀释液的振荡幅度、时间和次数以及放置时间等均作了比较具体的规定。
检验方法参见:GB4789.2-94 《中华人民共和国国家标准食品卫生微生物学检验菌落总数测定》SN0168-92 《中华人民共和国进出口商品检验行业标准出口食品菌落计数》三、说明(一)样品的处理和稀释:1.操作方法:以无菌操作取检样25g(或25ml),放于225mL灭菌生理盐水或其他稀释液的灭菌玻璃瓶内(瓶内预置适当数量的玻璃珠)或灭菌乳钵内,经充分振要或研磨制成1:10的均匀稀释液。

菌的检测方法菌是一类微生物,广泛存在于自然界的各种生物体中,对人类健康和环境具有重要影响。
为确保食品安全、环境卫生和医疗卫生的需要,菌的检测成为必要的工作。
本文将介绍几种常用的菌的检测方法。
二、传统培养法传统培养法是一种常见的菌的检测方法。
其主要步骤包括样品采集、接种培养基、培养、菌落计数等。
首先,从待测样品中采集菌落并转移到培养基上。
然后,将培养基置于适宜的温度和湿度条件下,培养一定时间后观察菌落的形成和生长情况。
最后,通过菌落计数来确定待测样品中菌落的数量并进行分析。
三、分子生物学方法近年来,随着分子生物学技术的发展,分子生物学方法也被广泛应用于菌的检测中。
其中,聚合酶链反应(PCR)是一种常用的分子生物学方法。
该方法通过特定引物选择性地扩增待测样品中的目标基因序列,然后使用凝胶电泳等技术进行目标基因的检测和分析。
相比传统培养法,分子生物学方法具有更高的灵敏度和特异性,能够检测到更低浓度的菌,并且不受菌种生长条件的限制。
四、免疫学方法免疫学方法是另一种常用的菌的检测方法。
该方法基于菌体表面的抗原与特异性抗体的结合,通过免疫反应来检测菌的存在。
常见的免疫学方法包括酶联免疫吸附测定法(ELISA)和免疫荧光技术。
这些方法具有快速、准确的特点,可以进行大规模样品的高通量检测。
五、快速检测方法为了满足现代社会对快速、便捷、准确的菌检测需求,一些快速检测方法也被提出和发展。
比如,基于光学传感技术的生物传感器,利用菌体与传感器之间的相互作用来快速检测菌的存在。
同时,一些生物芯片技术也应用于菌的检测中,通过微小芯片上的微阵列来同时检测多个菌种。
综上所述,菌的检测是确保食品安全、环境卫生和医疗卫生的关键环节。
传统培养法、分子生物学方法、免疫学方法以及快速检测方法都是常用的菌的检测方法。
在选择适合的方法时,需要考虑样品的特点、检测的目的以及实验条件等因素。
在未来,随着技术的不断进步和创新,菌的检测方法将更加多样化和高效化,为人类保障健康提供更强有力的支持。

卫生环境检验指标卫生环境检验指标是指对特定环境下的生物学、化学和物理指标进行检验,以评估该环境是否符合卫生标准。
这些指标广泛应用于各个领域,包括食品卫生、水质检测、室内空气质量等。
下面将详细介绍一些常见的卫生环境检验指标。
一、生物学指标1.细菌总数:用于评估环境中的微生物负荷情况,通常以大肠杆菌为指示菌,通过采样、培养和计数来确定环境中的细菌数目。
2.霉菌总数:用于评估环境中霉菌的负荷情况,通常以接种培养基来培养霉菌,然后通过计数来确定霉菌的数目。
3.细菌群落结构:通过分析环境中的细菌DNA,可以了解细菌群落的组成和结构,进一步评估环境的微生物多样性。
二、化学指标1.pH值:用于评估液体环境的酸碱度,pH值越低表示酸性越强,pH 值越高表示碱性越强。
2.溶解氧:用于评估水体中的氧气含量,生物在水中需要氧气进行呼吸,溶解氧低可能导致水体富营养化和水生生物死亡。
3.悬浮物质:用于评估液体中的颗粒物含量,高水平的悬浮物质可能导致水体浑浊以及水体富营养化。
4.重金属:用于评估环境中重金属元素的含量,一些重金属如铅、汞等对人体有害,超标可能导致健康问题。
三、物理指标1.温度:用于评估环境中的温度状况,高温或低温都可能对生物和人体造成不利影响。
2.湿度:用于评估环境中的湿度状况,不同环境对湿度有不同的要求,过高或过低的湿度可能导致问题。
3.光照强度:用于评估环境中的光照状况,不同生物对光照的要求不同,过强或过弱的光照都可能对生物产生不利影响。
4.噪声:用于评估环境中的噪声水平,长期暴露在高噪声环境下可能导致听力问题和其他健康问题。
以上仅是一些常见的卫生环境检验指标,实际应用中还会根据具体情况选择适合的指标进行检测。
另外,各个国家和地区对于卫生环境的标准和要求也会有所不同,因此在进行环境检验时需要参考相关的法律法规和标准要求。
沉降菌检查原则操作规程1.目旳本文献规定了干净室(区)中沉降菌检查旳操作措施,保证检查人员操作规范化、原则化,保证干净室干净度。
2.范畴原则规定了医药工业干净区中沉降菌旳测试条件、测试措施。
本原则合用于医药工业干净室(区),无菌室(区)(涉及干净工作台)旳沉降菌测定。
我司规定对万级净化实验室沉降菌检测项目进行一星期/次旳检查。
3.职责QC操作人员、QC管理人员严格按照此规程执行;有关使用人员做好干净室清洁维护工作。
4.内容4.1. 定义4.1.1.干净室(区)对尘埃及微生物污染规定需进行环境控制旳房间或区域。
其建筑构造、装备及其使用均具有减少对区域内污染源旳介入、产生和滞留旳功能。
4.1.2.干净工作台一种工作台或者与之类似旳一种封闭围档工作区。
其特点是自身可以供应通过过滤旳空气或气体,垂直层流罩、水平层流罩、垂直层流干净工作、水平层流干净工作台、自净器等。
4.1.3.干净度干净环境内单位体积空气中含不小于或等于某一粒径旳悬浮粒子旳容许记录数。
4.1.4.菌落细菌培养后,由一种或几种细菌系列而形成旳一细菌集落,简称CFU。
一般用个数表达。
4.1.5.沉降菌用本原则提及旳措施收集到旳活微生物粒子,通过专用旳培养基,在合适旳生长条件下繁殖到可见菌落数。
4.1.6.静态测试干净室(区)净化空气调节系统已处在正常运营状态,工艺设备已安装,干净室(区)内没有生产人员旳状况下进行旳测试。
4.1.7.动态测试干净室(区)已处在正常状态下进行旳测试。
4.2. 测试措施4.2.1.措施概述采用沉降法,即通过自然沉降原理收集在空气中旳生物粒子于培养基平皿,经若干时间,在合适旳条件下让其繁殖到可见旳菌落进行计数,以平板培养皿中旳菌落数来鉴定干净环境内旳活微生物数,并以此来评估干净室(区)旳干净度。
4.2.2.测试仪器和设备高压蒸汽灭菌锅、恒温培养箱、培养皿。
4.2.3.培养基营养琼脂培养基:培养基旳准备及灭菌根据培养基配制及敏捷度测试原则操作规程准备。
公共卫生测定微生物的检测标准
公共卫生测定微生物的检测标准涉及到多个方面的指标,主要包括以下几类:
1. 菌落总数:这是指示公共卫生状况的重要指标之一,用于评估样品中总微生物的数量。
2. 大肠杆菌计数:大肠杆菌是肠道中的一种细菌,其数量可以反映肠道健康状况。
3. 大肠菌群计数:大肠菌群包括一些对人体无害的细菌,但其数量过多也可能表明卫生问题。
4. 肠道致病菌(沙门氏菌、志贺氏菌、金黄色葡萄球菌):这些细菌是导致肠道疾病的主要病原体,检测它们有助于预防和控制疾病传播。
5. 单核细胞增生李斯特氏菌、双岐杆菌、副溶血性弧菌、空肠弯曲菌等其他致病菌:这些也是常见的病原体,需要定期检测以确保公共卫生安全。
6. 霉菌计数和酵母计数:霉菌和酵母过多可能表明环境卫生状况不佳,也可能对人体健康产生影响。
在具体实施检测时,应遵循相关标准和规范。
例如,对于微生物限度检验仪的标准可参考JB/T;对于微生物肥料的标准可参考NY和GB等。
请注意,这些只是一些常见的检测指标和标准,具体的检测项目和标准可能会根据地区、行业和特定情况而有所不同。
因此,在实际操作中,应遵循当地的相关法规和标准,以及专业人员的指导。
细菌的一般检验方法细菌是一类微生物,其存在对人类和动植物的生长发育、食品的加工贮藏和环境的卫生安全等方面都具有重要的影响。
因此,对细菌的检验成为了保障公共卫生安全和食品安全的重要手段。
细菌的一般检验方法包括了样品采集、预处理、培养、鉴定和计数等步骤。
首先,样品采集是细菌检验的第一步。
样品的采集应当严格按照规范进行,以避免外界污染的介入,影响检验结果的准确性。
不同类型的样品需要采用不同的采集方法,比如空气中的微生物可以通过空气采样器进行采集,而食品和水样则需要进行样品的取样和保存。
其次,样品的预处理是为了提高细菌的检出率。
预处理的方法包括了样品的稀释、过滤、离心、酶处理等。
这些方法可以去除样品中的干扰物质,使得细菌更容易被检测出来。
然后,培养是细菌检验的关键步骤。
将样品接种在含有营养物质的培养基上,利用恒温箱进行培养,有利于细菌的生长和繁殖。
不同的培养条件可以选择不同的培养基,比如选择富含营养物质的富养分琼脂培养基用于一般微生物的培养,选择含有特定抑菌剂的培养基用于选择性培养。
接下来是鉴定,即对培养后的细菌进行鉴定和分类。
鉴定的方法包括了生化试验、形态学观察、生理生化特性检测、分子生物学方法等。
通过这些方法,可以对细菌的种属进行初步鉴定,从而为后续的处理和控制提供依据。
最后是计数,通过计数可以了解样品中细菌的数量。
常用的计数方法包括了平板计数法、膜过滤法、MPN法等。
这些方法可以对样品中的细菌数量进行定量分析,为后续的风险评估和控制提供依据。
总的来说,细菌的一般检验方法包括了样品采集、预处理、培养、鉴定和计数等步骤。
这些方法的准确性和可靠性对于保障公共卫生安全和食品安全具有重要的意义,因此在实际操作中需要严格按照规范进行操作,以确保检验结果的准确性和可靠性。